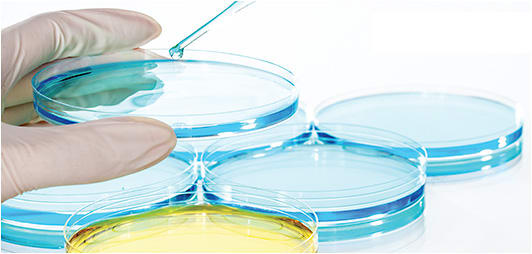
There doesn’t have to be a fungus among us. IMAGE COURTESY STOCK.ADOBE.COM / PR IMAGE FACTORY

Positive fungal rim cultures on donor corneal tissue at the time of endothelial keratoplasty (EK) are highly correlated with the subsequent development of clinical fungal infections. This can be a devastating complication, leading to blindness and loss of the eye.
The study, “Increasing Povidone-Iodine Exposure in Endothelial Keratoplasty Tissue Processing and Fungal Infection Impact,” reveals how a small change in the corneal tissue recovery process can significantly decrease the risk of postoperative fungal infections during corneal transplantation.1
Here, I provide an overview of this study, and its value to corneal specialists.
Overview
The study, published in Cornea, in September 2019, sought to assess the effect on donor rim cultures and postop fungal infections of doubling the 5% povidone-iodine exposure time during corneal tissue recovery from a single 5-minute soak to 2 separate 5-minute soaks.
Results revealed that prior to the protocol change, 631 consecutive donor corneal tissue recoveries resulted in 18 (2.9%) positive fungal rim cultures and 3 (0.48%) subsequent postoperative fungal infections. After the protocol was changed to 2 separate 5-minute soaks, 725 consecutive donor corneal tissue recoveries resulted in 4 (0.6%) positive fungal rim cultures and zero postoperative fungal infections. Additionally, no increase in corneal toxicity was noted between the two groups. This suggests the additional povidone-iodine exposure does not cause adverse events to the corneal tissue or corneal epithelium.
Value
Although fungal infection after EK is rare, it does occur and can result in decreased vision and permanent blindness. The study, “Increasing Povidone-Iodine Exposure in Endothelial Keratoplasty Tissue Processing and Fungal Infection Impact” showed that doubling the 5% povidone-iodine exposure time during corneal tissue recovery decreased the rate of positive donor corneal tissue rim fungal cultures (P=0.001) and postoperative fungal infections (P=0.06).
I think this is especially important, as the popularity of EK increases: Postkeratoplasty fungal infections have been shown to be common in EK-processed tissues. This was also the case in the published study.
The Eye Bank Association of America (EBAA) advisory board seconded a motion to revise the EBAA Medical Standard E1.100, which makes recommendations on how eye banks should perform corneal tissue recovery. The revision states that 5% povidone-iodine should come in contact with the donor tissue “at least twice.”
While many ongoing studies are being conducted to optimize an effective antifungal supplement that can be added to corneal tissue storage media, the double betadine soak technique is a safe and cost-effective solution to postoperative fungal infections. CP
Reference:
- Salisbury CD, Kirk CN, Lee WB, et al. Increasing povidone-iodine exposure in endothelial keratoplasty tissue processing and fungal infection impact. Cornea. 2019;38(9):1093-1096.









